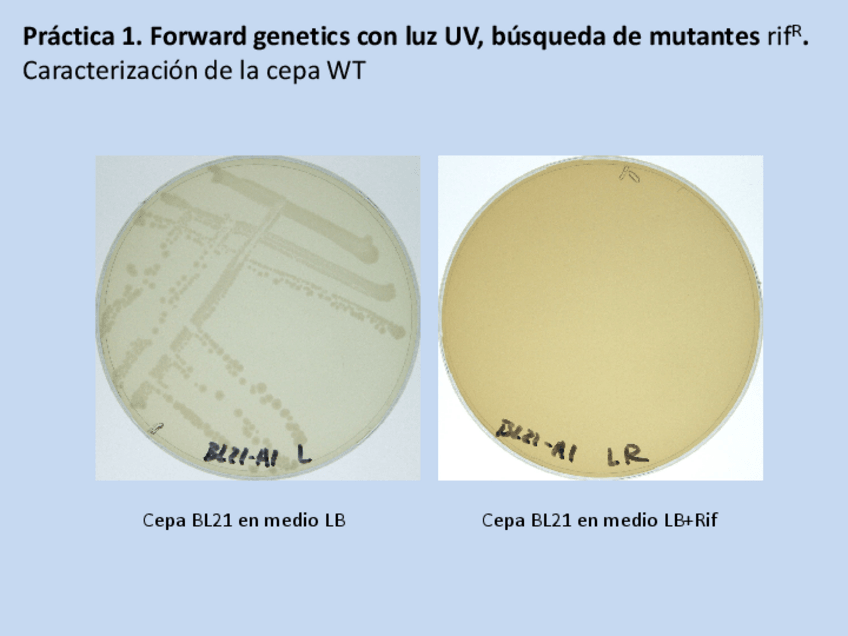

@Liverwort
Bio: Be water, my friend.
129 Publicaciones
15.39k Interacciones
9 Seguidores
0 Siguiendo
Lista de publicaciones de Liverwort
He publicado nuevos apuntes de 4º Inmunología: Apuntes-Tema-6-Anticuerpos.pdf
He publicado nuevos practicas de 4º Biotecnología Microbiana: INFORME-RESULTADOS.pdf
He publicado nuevos practicas de 3º Biología Molecular: Resultados-Practicas-GM-2020.pdf
He publicado nuevos examenes de 3º Biología Molecular: Exm-26-Enero-2021.pdf
He publicado nuevos examenes de 3º Biología Molecular: Examenes-seminarios.pdf
He publicado nuevos examenes de 3º Biología Molecular: EXM-Preguntas-desarrollo-y-Respuestas-.pdf
He publicado nuevos examenes de 3º Regulación del Metabolismo: Seminarios-de-Regu.pdf
apuntes
-
Esquemas generales RM
He publicado nuevos apuntes de 3º Regulación del Metabolismo: Esquemas generales RM
He publicado nuevos apuntes de 3º Regulación del Metabolismo: Preguntas-evaluacion-temas-7-14.pdf
apuntes
-
Esquemas Micro
He publicado nuevos apuntes de 3º Microbiología: Esquemas Micro
apuntes
-
TEORÍA REGULACIÓN DEL METABOLISMO
He publicado nuevos apuntes de 3º Regulación del Metabolismo: TEORÍA REGULACIÓN DEL METABOLISMO
He publicado nuevos apuntes de 3º Regulación del Metabolismo: Resumen-enzimas.pdf
He publicado nuevos practicas de 3º Regulación del Metabolismo: REGU-Practicas.pdf
ejercicios
-
PREGUNTAS DE SEMINARIO RESUELTAS
He publicado nuevos ejercicios de 3º Fisiología: PREGUNTAS DE SEMINARIO RESUELTAS
He publicado nuevos examenes de 3º Fisiología Vegetal: Preguntas-de-seminarios-FV.pdf
He publicado nuevos practicas de 3º Genética Evolutiva: GENETICA-EVOLUTIVA-PRACTICAS.pdf
He publicado nuevos examenes de 3º Fisiología: EXAMEN-PRACTICAS-FISIOLOGIA.pdf
He publicado nuevos practicas de 3º Microbiología: Apuntes-practicas-micro-2C.pdf